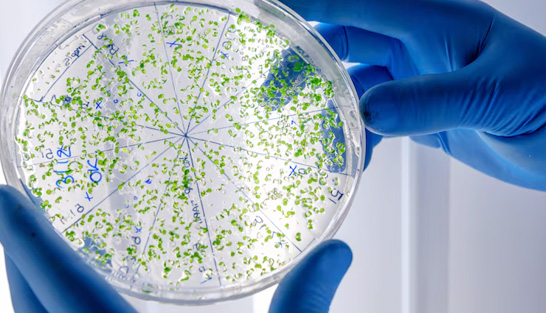

您的位置: 首页 > 臻选产品

去离子纯水机
常规分析用纯水的卓越选择!
以自来水为进水,可直接生产出纯水和去离子水
产水量:10/15/20/30/45/60升/小时
去离子水电阻率:16-18.25MΩ.cm
表
里
如
一
・
卓
越
效
能
应用范围
微生物培养基的配制
缓冲液配制
水栽法
制备化学和生化试剂
火焰法原子吸收
实验室设备的供水(高压高温灭菌器、清洗机、全自动生化分析仪、免疫分
析仪、恒温恒湿箱、盐雾试验箱、老化仪、加湿器等)
技术参数
产品型号 |
P-10L |
P-15L |
P-20L |
P-30L |
P-45L |
P-60L |
| 纯水产量* | 10L/Hour | 15L/Hour | 20L/Hour | 30L/Hour | 45L/Hour | 60L/Hour |
| 瞬间出水量 | 高达2.0L/Min(水箱有水时) | |||||
| 进水要求* | 城市自来水:电导率<400μs,5-45℃,1.0-4.0Kgf/cm²(进水电导率>400μs时,建议选配外置软化器) | |||||
| DI 去离子水指标 | ||||||
| 电阻率(25℃) | 16-18.25MΩ.cm | |||||
| 重金属离子 | <0.01ppb | |||||
| 细菌 | N/A | N/A | N/A | N/A | N/A | N/A |
| 颗粒物(>0.22μm) | N/A | N/A | N/A | N/A | N/A | N/A |
| RO 反渗透纯水指标 | ||||||
| 离子截留率 | >98%(使用新RO膜) | |||||
| 有机物截留率 | >99%,当MW>200道尔顿 | |||||
| 颗粒和细菌截留率 | >99% | |||||
| 尺寸/重量 | 长 × 宽 × 高:540×390×640mm/重量:约 30Kg | |||||
| 电气要求 | 100-240V, 50/60Hz | |||||
| 功率 | 120W | |||||
| 系统配置 | 主机(含全套耗材+内置压力水箱)+附件包 | |||||
系统特性




具有手动取水及定量取水两种取水方式可选择,取水操作更人性化
取水时显示当前取水流量、累计取水量、取水水质、水温以及水箱储水量,让您掌握每次的取水信息
超纯水取用时,如低于您对水质要求的设定值,系统将使超纯水循环净化,直到水质达标
定量取水功能,从10ml-999999ml任意设定
定质取水功能,从1-18.25 MΩ.cm任意设定
水质全面监控在线三路水质监控,实时监测进水电导率、纯水电导率、超纯水电阻率以及温度
三路水质监测异常时自动报警并显示(参数可设定)
高精度电导和电阻率监测仪,电导电极常数达到1.0cm-1,电阻电极常数达到0.02cm-1,带温度自动补偿功能,温度灵敏度达到0.1℃,确保水质监测的准确性
耗材管理PP、AC预处理柱、RO反渗透柱、UP纯化柱、UV紫外灯、UF超滤膜的使用寿命均可自行判断(寿命可设定),并可查询耗材已经使用时长、处理水量及更换日期
耗材均带有编码,系统可储存和查看耗材更换信息,方便耗材日常维护
系统报警系统具有完善的报警管理功能,主要管理进水、纯水及超纯水水质、进水压力和所有耗材的寿命等报警,报警发生时,自动弹出报警界面,显示并储存报警信息
完善的内循环及加药消毒系统超纯水内循环系统,时刻保证取得稳定的水质(循环功能可根据您的要求,随时开启或关闭)
超纯水全管路加药消毒系统,可实现循环消毒、取水口消毒、水箱补水、手动排污
数据的可追溯性系统可自动储存历史系统报警、历史取水水质信息、耗材使用情况等记录,通过USB Host数据接口进行完整的数据导出,实现数据的可追溯性
 定制您的专属解决方案
定制您的专属解决方案
莱特莱德专业提供实验室超纯水机、中央超纯水机、临床医院用超纯水机等生产、销售及售后服务。